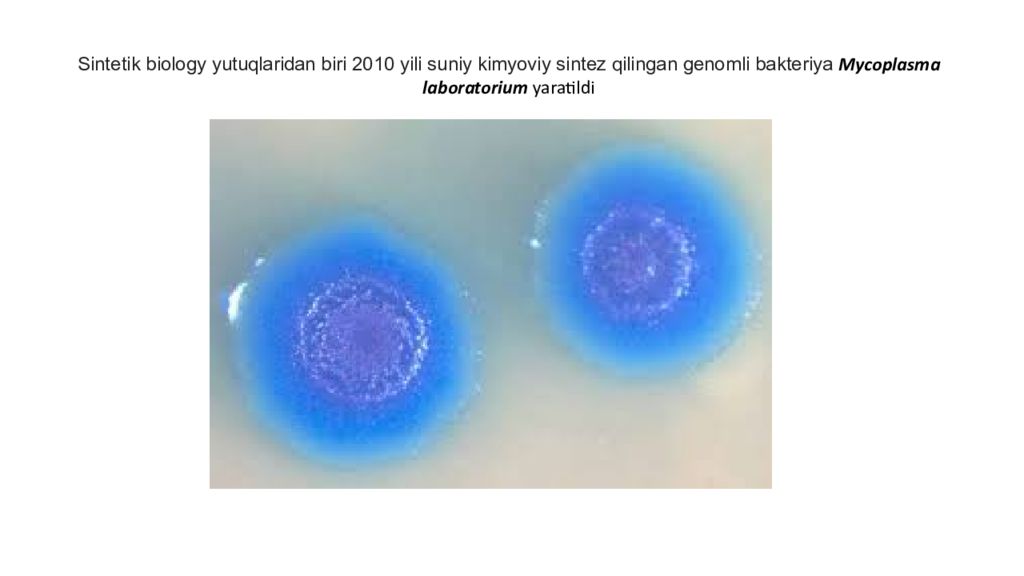
DNK ning tuzilishi va DNK replikatsiyasi DNK ning tuzilishi va DNK replikatsiyasi

Слайд 2: DNK ning tuzilishi va DNK replikatsiyasi
1. DNK ning tuzilishi Azotli asoslar. Nukleozidlar. Nukleotidlar DNK qo'sh spirali, Gistonlar 3 tali va 4 tali DNK spiral, nostabil nukleotidlar sintetik biologiya ( SynBio ), suniy genlar sintezi, genetik alfavitni kengaytirish, Xeno nucleic acid(XNA), biohakerlar. 2. DNK replikatsiyasi Ori genlar Telomerlar telomeraza
Слайд 3
Azotli asoslar. Nuklein kislotalarining azotli asoslari kimyoviy tuzilishiga ko ra 2 guruhga - purin va pirimidin asoslariga boTinadi. Ularning orasida siyrak (minor) purin va pirimidinli asoslar mavjud. Eng muhim purin asoslariga - adenin (A) va guanin (G); pirimidinlarga esa - sitozin (C) timin (T) kiradi. DNK tarkibiga A,G,C,T;
Слайд 4: Nukleozidlar. Azotli asosning pentoza bilan birikishidan hosil bo’lgan moddaga nukleozid deb aytiladi
Слайд 5: Nukleotidlar. Nukleozidlarni fosfat kislota qoldig i bilan birikishidan nukleotidlar hosil boTadi, ya'ni nukleotid tarkibi - azot asosi, uglevod qoldig ’ i va fosfat kislotadan iborat
Слайд 6
Nukleotidlarda 1-2-3 ta fasfat kislata qoldigi bo’lishi mumkin. Fasfat kislata ajraganda inergiya chiqadi.
Слайд 7
Siklik nuklein kislatning tuzilshi Siklik AMF va siklik GMF organizmda ikkilamchi mesenjir vazifasini bajaradi, retseptorlardan kelgan signalni hujayra ichida tarqalishini taminlaydi 5’ 3’ 5’ 3’
Слайд 9
DNK tuzilishi haqida gapirganimizda bir oz uning tarihi haqida aytib o’tishimiz joiz. 1951 yili DNK molekulasi ning dastlabki rentgenogrammalari ingliz olimlari M.Uilkins va R.Franklin tomonidan olingan edi. Lekin R.Franklin o’zi bu rasimlarni tahlil qilishga ulgurmadi.
Слайд 10
Jadallik bilan olib borilgan tadqiqotlar 1953 yili Dj. Uotson va F. Krik tomonidan DNK qoʼsh spiralli modelining yaratilishi bilan yakunlandi. Ular R.Franklin tomonidan olingan suratlarni tahlil qilib DNK tuzilishini hisoblab topishdi. 1962 yili Dj. Uotson, F. Krik F va Uilkinsomlarga DNK tuzilishini ochgani uchun Nobel mukofoti berildi. Afsuski R.Franklin nomi tilga ham olinmadi.
Слайд 11: Rozalin Franklin 1958 chi yili nurlanishdan saraton bo’lib olamdan ko’z yumdi
Слайд 14
Gistonlar Nukleosomalar, xajmlanishning birinchi darajasi. DNK ning qoʼsh spirali giston oqsillari kompleksini ikki bor aylanib joylashadi. Matias Bader (Mathias Bader) illyustratsiyasi
Слайд 17
Gistonlar Odam genomi uzunligi 2 metrni tashkil qiladi. Shunga qaramay u gistonga o’ralgani uchun ixchamlashib hujayra ichiga sig’a oladi. Ishlashi kerak bo’lgan genlar esa gistonlari N terminal qismi fasfatlanish va atsillanish kabi kimyoviy modifikatsiyaga uchraydi va DNK yechiladi. Gen aktivlashib undan RNK sintez buladi. Bu esa gistonlarning genlar ekspressiyasi boshqarilishida ishtrok etishini ko’rsatadi.
Слайд 18: Uch zanjirlik DNK spirali
http://mol-biol4masters.masters.grkraj.org/html/Deoxy_Ribonucleic_Acid3-Other_Forms_Of_DNA.htm Uch zanjirlik DNK bir nechta genlarni tartibga solishda ishtirok etadi. genni inaktivatsiya qilishi yoki yo’naltirilgan mutatsiyalar hosil bo’lishga yordam berishi mumkin.
Слайд 19: To’rt zanjirlik DNK spirali
G- kvadrupleksa guaninga boy joylarda xosil bo’ladi tabiatda ko'pincha xromosomalarning oxirida telomer deb nomlanuvchi qisimlarda va ko'plab genlarning transkriptsional tartibga soluvchi qisimlarda uchraydi.
Слайд 20: nostabil nukleotidlar
Inozin va guanin uchun nostabil o’zgaruchi asoslari juftlari Polimeraza zanjirli reaksiya primerlar dizaynida inozin ning har qanday nukleotid bilan birlashishi dan foydal aniladi. Bu primerni yopishish temperaturasini buzmasdan bitta nukleotid polimorfizmi ( 1 nukleotid farqi ) bo’lsa ham PCR ketishishi taminlaydi.
Слайд 21: sintetik biologiya ( SynBio )
Sintetik biologiya-biotexnologiya, gen muhandisligi, molekulyar biologiya, molekulyar muhandislik, tizimlar biologiyasi, membranalarshunoslik, biofizika, kimyoviy va biologik muhandislik, elektrotexnika va kompyuter texnikasi, boshqarish muhandisligi. va evolyutsion biologiya kabi yo’nalishlarni o’z ichiga oladi. Ushbu soha DNK sintezidan foydalanib ilgari tabiatda mavjud bo’lmagan yangi sistemalarni yartishi mumkin. Bu esa ko’plab ekologik muammolarni hal qilishi mumkin.( plastiklarni parchalay oladigan, taksinlarni zararsizlantradigan suniy fermentlar sistemasi ) Odatga 2 qisimga bo’linadi : gen ingeneryasi, bioinformatika, prateomika orqali hujayra ichdan metabalizmni o’zgartisrish. Ichkaridan programmalashtirish. Fermentlar, nanozarrachalar, membranalar orqali suniy hujayra timsolini yaratib sanoatda malum funksyani bajarish. Suniy membranalar, fermentlarni imobillash, hujayrasiz oqsil sintezi shu yo’nalishga kiradi. Kelajagda suniy buyrak, suniy jigar yaratish imkonini beradi. 2016 yilda sintetik biologiya bilan 40 mamlakatdan 350 dan ortiq kompaniyalar shug’illanmoqda ; ushbu kompaniyalarning jahon bozoridagi ulushi 3,9 milliard dollarga baholanmoqda
Слайд 22: suniy genlar sintezi
Oligonucleotide synthesis Kimyoviy reaksa yordamida 40-50 bp lik 1 zanjirlik DNK sintez qilinadi ( oligonuklerid ). Ushbu fragmentlar polemeraza va ligaza orqali bir birga tikiladi, sintez qilingan genlar hajmi 600 dan 1200 bp gacha yetadi
Слайд 23: 1-usulda 1 kb kattaligdagi fragmentlar bir birga IIS tipdagi restrektazalar orqli ulanadi
Слайд 25: genetik alfavitni kengaytirish
2012 yilda Kaliforniya shtatidagi San-Diego shahridagi Scripps tadqiqot institutining kimyoviy biologi Floyd Romesberg boshchiligidagi bir guruh amerikalik olimlar uning jamoasi suniiy juftlik yaratganligini e'lon qilishdi. dNaM –d5SICS o’zaro komplementar bo’lib, polemeraza tasirida replikatsiya qila oladi. 2014 yili ushbu jamoa dNaM –d5SICS kiritilgan plazmidani E. Coli ga kiritib bir necha avlodda normal ko’payishini kuzatdi. Hozirda ushbu moddalarni metabalizim bilan sintez qilish iloji yuq. Yuqoridagi eksperimentda suv o’tining nukleotidtrifosfat transportyor geni E. Coli ga kiritilgan edi. Shuning uchun bakteriya tashqaridan d5SICSTP va dNaMTP ni samarali ravishda import qiladi va plazmidani replikatsiya qila oldi. doi : 10.1073/pnas.1205176109 doi : 10.1038/nature13314 Bu sohada ko’pgina izlanishlar olib borilmoqda. Bunday suniy nukleotidalrdan yasalgan virus va vaksinalar juda yuqori xafsizlikga ega bo’ladi. Chunki bunday moddalar tabiy organizmda mavjuda emas. Shuning uchun Virus replikatsiya qila olmaydi. dNaM –d5SICS
Слайд 26: Xeno nucleic acid (XNA)
Xeno nucleic acid (XNA) Deoxyribonucleic acid (DNA) XNAlar vakillaridan biri peptide nucleic acid (PNA) aminoetilglisin dan tuzulgan Ikkinchisi morpholino (MO) Xozirgi kunda XNA larning sut emizuvshilar hujayra kulturasida in vitroda tekshirib ko’rilgan. XNA lar ken diapazondagi pH ko’rstgichiga chdamli, nukleazalat tanib olishi qiyin, temperaturaga chidamliy bo’lgani uchun sitazoldagi nukleotidlar dastavkasini yaxshilashi mumkin
Слайд 27
Sintetik biology yutuqlaridan biri 2010 yili suniy kimyoviy sintez qilingan genomli bakteriya Mycoplasma laboratorium yaratildi
Слайд 28
DIYbio biohakerlar sayti bo’lib - Veb-sayt havaskor biolog uchun manbalarni taqdim etadi. U yig'ilishlar o’tqazishadi va jamoat laboratoriyalariga xizmat ko'rsatuvchi tashkilotlarni va ushbu tashkilotlar tomonidan o'tkaziladigan blog tadbirlarining haftalik ro'yxatini yuritadi. biohacking Bioxakerlar aslida zarar keltirish uchun emas, balki yangicha ijodiy yondoshish, malumotlarni bepul almashish, shu sohani rivojlanishini taminlash, odamlarni biologyaga qiziqtirish maqsadisa ish olib borishadi. O’z vaqtida kompyuterlar xam bepul malumot almashinish orqali tuda jadal rivojlangan edi. Aks xolda olimlar o’z ixtrolarini xammadan yashirib utraverishadi. Bazida malumot almashinish ham sohani rivojlanishiga o’z xissasini qo’shishi mumkin. sci -hub sayti ham shu felosofik qarashlar tarafdorlari tomonidan yaratilgan.
Слайд 29
5' va 3' bu dezoksiribozadagi uglerod soni. qaysi uglerod bilan bog'langanligi DNK replikatsiyasi
Слайд 30
DNK replikatsiyasi ko'paytirish vilkalari sxemasi. a: shablon, b: etakchi ip, c: orqada qoluvchi ip, d: ko'paytirish vilkasi, e: praymer, f: okazaki bo'laklari
Слайд 31
DNK replikatsya sxemasi 1 topoizomeraza ( giraza ) - dnk dagi fosfodiefir bog'ni uzib spiralini yoyib ulab chiqadi 2 xelikaza - H boglani uzadi 3 single strand binding - helikaza ajratgan zanjir qaytib yopishmasligini ta‘minledi 4 DNA primerasa. RNK praymer sintez qiladi 5 DNK polimeraza III – 5’ dan 3’ tomon praymerdan boshlab DNK sintezlaydi 6 jarayon 2 xil borishi mumkin A) egzonukleaza - RNK praymerni parchalab tashlaydi DNK Polimeraza – xosil bo’lgan bo’shliqga DNKni sinetzlaydi B) DNK polimereza I - RNK praymerni o’zi parchalab bo’sh qolgan joyga DNK sintezlab qo’yadi 7 DNK Ligaza - hosil bolgan DNK lar orasidagi fosfodiefir bog’ini ulaydi
Слайд 32
topoizomeraza fermenti DNK zanjiridani tekkizlaydi. DNK dazmollanganday tekkiz bo'lib qoladi. xelekaza fermenti esa DNK 2 zanjiri o'rtasidagi vodorod bog'larni uzadi Topoizomeraza fermendi DNK dagi fosfodiefir bog'ni uzadi. DNK nina aypantirib yana tikib quyadi. oqibatda DNK spirali tekizlanadi
Слайд 33: DNK Polemeraza
Birinchi marta 1956 yilda Kornberg tomonidan kashf etilgan. Escherichia coli bakteriyalari Bakteriyalarda 3 turi mavjud DNK Pol I, II va III DNK Pol III- DNK replikatsiyasida ishtirok etadi DNK Pol I- DNK ta'mirlash bilan shug'ullanadi Odamlar 4 turga ega ( hozir bilishingiz kerak ) DNK Pol alfa, beta, delta - yadroviy DNK DNK Pol gamma - mitoxondriyal DNK
Слайд 34: DNK Polemeraza …
Hamma DNK Polemerazalari 2 ta xususiyatga ega 5 ' dan 3' ga yo'nalishda DNKni sintez qiling Faqat mavjud bo'lgan DNKning matritsasidan nusxa oladi. Shuning uchun ular DNK sintezini noldan boshlay olmaydilar. RNK polimerazalar matritsasiz sintez qilishi mumkin, lekin DNK polimerazalar emas.
Слайд 35
Prokariotlarda DNK replikasiyasi Bu videoda bakterial hujayralarda sodir buladigan DNK replikasiyasi haqida qishqacha ma'lumot berilgan. https://youtu.be/FgoZSgp-d7I Prokariot va Eukaryotlar DNK Replikasiyasidagi farqlar va uxshashliklar https://youtu.be/28q5oACYRCw DNA replikatsiyasi - 3D animatsiya https://youtu.be/TNKWgcFPHqw Ushbu vidioda praymerlar egzonukleaza orqali parchlanadi https://youtu.be/IjVLhoyfGAM Ushbu vidioda esa polemeraza I orqali parchlanadi
Слайд 36: Ori gen
Bakteriyalar (A) va eukaryotlar (B) ning DNK replikatsiyasini boshlash modellari. A) Dumaloq bakterial xromosomalarda replikatsiya manbalarida yoki ularga yaqin joylashgan replikator element mavjud. i) replikator initsatsalovchi oqsillarni DNK ketma-ketligiga mos tarzda yopishadi, natijada DNK spirali yoziladi va replikativ helikaza DNKning har bir zanjiriga ( ii ) ulanadi. iii ) Hosil qilingan replika s omalar ikki yo'nalishda DNKni replikatsiya qilib, bakterial xromosomaning ikki nusxasini hosil qiladi. B) Chiziqli eukaryotik xromosomalarda ko'plab replikatsiya manbalari mavjud. initsatsiatorni bog'lash (i) replikativ helikazni bog’lanishini osonlashtradi ( ii ) dupleks DNKga bog’lanishini osonlashtiradi. iii ) bog’langan helikazlar repli soma yaratish uchun faollashtiriladi. Replikatsiya ikki yo'nalishda sodir bo'ladi va qo'shni faol manbalardan ( iv ) ko'payish shoxlariga duch kelganda to'xtaydi. Eukariotlarning chiziqliy xramasomasi oxirida telomerlar mavjud.
Слайд 38: replikatsiya ko'zi bir neshta joyda bo'lishi mumkin. bu replikatsya tezligini oshradi
eukaryotik lar genom i 12 Mbit / s dan ( S. cerevisiae-da ) 3 Gbit / s gacha ( odamlarda ) katta bo'lgan i uchun DNKning replikatsiyasini bir necha yuz joydan boshlashni talab qiladi.
Слайд 40: E COLI ori genlari ro’yxati
Common Vectors Copy Number + ori pUC ~500-700 pMB1 (derivative) pBR322 ~15-20 pMB1 pET ~15-20 pBR322 pGEX ~15-20 pBR322 pColE1 ~15-20 ColE1 pR6K ~15-20 R6K* pACYC ~10 p15A pSC101 ~5 pSC101 pBluescript ~300-500 ColE1 (derivative) and F1** pGEM ~300-500 pUC and F1**
Слайд 41
Sut emizuchilarda ori geni to’iq o’rganilmagan va u juda murakkab. Shuning uchun sut emizuchlarda genomga transfatmatsiya qislish uchun virusliy vektorlar ishlatiladi. Yoki umuman ori geni yo’q plazmida sihlatiladi. Chunki sut emizuvchlar hujayrasi 2 kunda 1 marotaba ko’payadi. Odatda in vitro eksperimentlar 24 soat ichda kuzatiladi xolos. Shuning uchun ori gensiz plazmidalarni ishlatish mumkin. Yana bir usuli Simian Virus 40 (SV40) origeni SV40 T- antigeni mavjud hujayralarda replikatsiya qila oladi. Epshteyn -Barr virusining (EBV) EBNA-1 geni ORI gen o’rnini bosishi mumkin. Subu ori genlar plazmidani replikatsiya qilishini taminlashi mumkin. EBNA-1 origeni xar gal hujayra ko’payganda 5% plazmida yuqotadi. Bu esa malum voxtdan so’ng plazmida butunlay yo’qolishiga olib keladi. SV40 ori SV40 ori EBNA-1 Ген : экспрессия EBNA-1 для инициации внехромосомной репликации с помощью oriP SV40 ori : ori gene репликации для внехромосомной репликации pUC ORI ( yoki ColE1 ori ) : E. coli da ko’payishi uchun. Chunki barcha vektorlar e colida ko’paytirib olinadi. Keyin achitqi, o’simlik yoki xayvonga kiritiladi.
Слайд 42: Mitaxondrya va xloroplastlarda replikatsiyasining ori geni qismida O H bo’ladi. U replikatsiya paytida D-loop hosil qiladi
Слайд 43: D-loop qismi Sequence qilinib felogeniya analizi uchun ishlatiladi
Mit23-F TCATTGGACAAGTAGCATCC 756 bp Mit23-R GAGTGGTTAATAGGGTGATAG Mit24-F CACCATCCTCCGTGAAATCA 954 bp Mit24-R AGGCTAAGCGTTTTGAGCTG
Слайд 44: Telomerlar
Har gal hujayra bo'linganda, xromosoma uchidagi telomerlar kichrayib boradi. Xeyflik chegarasi ( Hayflick limit ) - hujayraning bo'linish sonining nazariy chegarasidir, bunda telomerlar qisqarib bo'linish ingibirlanib qoladi va hujayra qarib nobud buladi. O'rtacha hujayra hujayra 50 dan 70 marta bo'linadi so’ng qarib o’ladi. 1961 yil doi : 10.1016/0014-4827(61)90192-6
Слайд 46: Telomerlar
In vitro da inson TRF2 orqali olingan T-loop ( Т elomeric Р epeat В inding Р akter 2 ).
Слайд 47: Telomeraza
Ferment Teskari transkriptaza DNK shablonisiz sintez qila oladi, chunki uning ichida o'z RNK shabloni bor (RNK li koferment ) Telomeraza fermenti telomerlani uzunligini tiklaydi. jinsiy hujayralarda, asos hujayralarda (stem cell) va rak hujayralarida telomeraza fermenti faol bo’ladi. Shuning uchun ular cheksiz kopayishi mumkin. Somatik hujayralar ushbu jarayon uchun telomeraza etishmaydi, shuning uchun ular telomer uzunligini yo'qotadi, bu hujayralar o'limiga olib keladi.
Слайд 48: Suniy xramasomaliy vektorlar
Plazmidlar va viruslarning hajmi cheklangani uchun xozirgi kunda bir necha genlar yoki katta fragmentlarni kiritish uchun suniy xramasomalr yaratilgan. Bu xramasomalar aslida Cre -Lox recombination usulida barcha genlari olib tashlangan, faqatgina ori gen va telomerlari qolgan tabiiy xramasomalar. Ular plazmida singari juda ko’p kopya xosil qilmaydi. Stabil ravishda xar gal hujayra bo’linganda 2 ga bo’linadi. Bacterial artificial chromosome( ВАС )- 150-350 kb lik E. Coli konstruksiyasi, F- plazmidaorqali olingan. U o’zida F- plazmidaning Ori genini saqlaydi. U sekin replikatsa bo’lib bakteriya hujayrasi bo’linganda teng taqsimlanadi. DOI : 10,1073 / pnas.89.18.8794 DOI : 10.2302 / kjm.50.26 P1-derived artificial chromosome( P АС ) 100-300- kb lik E. Coli konstruksiyasi, P1 bakteriofag DNK sidan olingan. DOI : 10.1073 / pnas.87.1.103 Yeast artificial chromosomes (YACs) 100 – 1000kb gacha fragmentni klonlash mumkin DOI : 10.1128 / mcb.1.6.535 human artificial chromosome (HAC) 6–10 mb o’lchamlik minixramasoma. ( tabiiy xramasoma 50-250mb) DOI : 10.1038 / mt.2008.253 DOI : 10.1016 / j.bbrc.2011.10.088 DOI : 10.1007 / s00018-012-1113-3